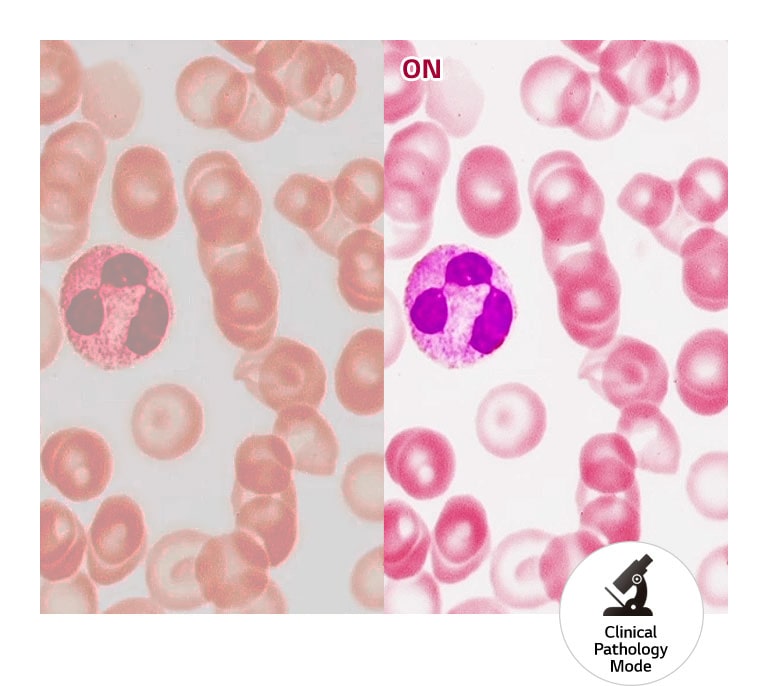
Realistic Colour Reproduction1

We use cookies, including cookies from third parties, to enhance your user experience and the effectiveness of our marketing activities. These cookies are performance, analytics and advertising cookies, please see our Privacy and Cookie policy for further information. If you agree to all of our cookies select “Accept all” or select “Cookie Settings” to see which cookies we use and choose which ones you would like to accept.
32” IPS Diagnostic Review Monitor
Images dramatised for illustrative effect.
All Spec
DISPLAY
Size [Inch]
31.5
Aspect Ratio
16:9
Surface Treatment
Anti-Glare
Response Time
5ms (GtG at Faster)
Resolution
3840 x 2160
Pixel Pitch [mm]
0.18159 x 0.18159
Viewing Angle (CR≥10)
178º(R/L), 178º(U/D)
Brightness (Typ.) [cd/m²]
450
Contrast Ratio (Typ.)
1300:1
Colour Gamut (Typ.)
DCI-P3 98% (CIE1976)
Colour Bit
10bit (8bit+FRC)
CONNECTIVITY
12G-SDI
NO
3G-SDI
NO
D-Sub
NO
DVI-D
NO
Component (Resolution)
NO
Composite (Resolution)
NO
HDMI
YES(1ea)
Daisy Chain
NO
DisplayPort
YES(2ea)
Thunderbolt
NO
Headphone out
NO
RS-232
NO
S-Video
NO
USB Downstream Port
YES(2ea/ver2.0)
USB Upstream Port
YES(1ea/ver2.0)
FEATURES
HDR 10
NO
Auto Luminance Sensor
NO
Smart Energy Saving
YES
PIP
NO
PBP
2PBP
Flicker Safe
YES
HW Calibration
HW Calibration Ready
Black Stabiliser
YES
Lighting
NO
Reader Mode
YES
Super Resolution+
YES
Hot Key
NO
Presence Sensor
NO
Front Sensor
NO
Colour Temperature
6500K/7500K/9300K/Manual(5000K-10000K)
Rotation & Mirror Mode
NO
Failover Input Switch
NO
Focus View
YES
Light Box Mode
NO
Brightness stabilisation
YES
Pathology Mode
YES
DICOM Compliant
YES
HDR Effect
NO
MECHANICAL
Display Position Adjustments
Tilt/Height/Pivot
Borderless Design
4-Side Virtually Borderless Design
Wall Mountable [mm]
100 x 100
OneClick Stand
YES
Machanical Power Switch
NO
DIMENSIONS/WEIGHTS
Weight in Shipping [kg]
11.4
Weight with Stand [kg]
7
Weight without Stand [kg]
5.6
POWER
Power Consumption (Max.)
65W
Power Consumption (DC Off)
Less than 0.3W
AC Input
100-240V (50/60Hz)
Type
External Power(Adapter)
DC Output
19V, 3.42A
ACCESSORY
Adapter
YES
Calibration Report (Paper)
YES
Display Port
YES
DVI-D (Colour/Length)
NO
D-Sub
NO
HDMI (Colour/Length)
YES
Power Cord
YES
USB3.0 Upstream Cable
NO
SW APPLICATION
Dual Controller
YES
LG Calibration Studio (True Colour Pro)
NO
Qubyx
YES
STANDARD
UL (cUL)
YES
CE
YES
RoHS
YES
IP(Front/Except for front)
NO
Vandal-proof
NO
KGMP
YES
KC (for Rep. of Korea)
NO
IEC (IEC 60601-1 / IEC 60601-1-2)
YES
EN (EN 60601-1 / EN 60601-1-2)
YES
IEC (IEC 60950-1 / IEC 55032, 55024)
YES
EN (EN 60950-1 / EN 55032, 55024)
YES
FDA
Class II
ISO13485
YES
GMP
YES
WEEE
YES
MFDS
YES
REACH
YES
What people are saying
Our Picks for You
Manual & Software
Download product manuals and latest software for your product.
Troubleshoot
Find helpful how-to videos for your product.
Warranty
Check your product warranty information here.
Part & Accessory
Discover accessories for your product.
Product registration
Registering your product will help you get faster support.
Product support
Find manual, troubleshoot and warranty of your LG product.
Order support
Track your order and check order FAQ.
Repair request
Repair request service conveniently online.